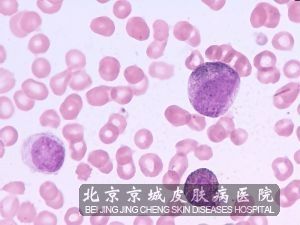

北京京城皮肤医院提供网络预约挂号服务
预约挂号热线:010-64888999
三级专科
医保定点
舒适环境
无假日
非淋菌性尿道炎综述,非淋菌性尿道炎是一种严重的性传播疾病,它是指由淋菌以外的其它病原体,主要是沙眼衣原体,尿素分解支原体所引起的尿道炎。这种疾病目前在欧美**已超过淋病而跃居性传播疾病首位,我国病例亦日益增多,成为较常见的性传播病之一。它的出现给患者造成了较大的危害,不仅影响正常的生活和工作,还给家庭带来困扰。这种疾病多见于女性,30 -40 男性,80 -90 女性无自觉症状,或者症状很轻未能引起患者注意。因此我们在日常生活中一定要注意时刻关注我们的身体变化,不要让疾病侵犯我们的身体,造成生活和工作的困扰。下面就来看看北京京城皮肤医院对非淋菌性尿道炎的综述。

非淋菌性尿道炎综述
非淋菌性尿道炎的病因:
1、不洁性生活传播:非淋是会直接的通过性生活传播的,只要和患有非淋的人进行性生活的话就会被传染,其传染性是非常强的。所以女性朋友需要引起重视,不能够出现滥交、卖淫等不良性生活。
2、产道传染:如果孕妇自身患有非淋是会通过产道将非淋病毒传染给新生儿的,导致新生儿一出生就携带非淋病毒,并且非淋还会通过胎盘、羊水传染给胎儿,导致胎儿死腹中。
3、外伤感染发炎:如果认得身体上出现伤口,此时非淋病毒就会通过皮肤、黏膜上破裂的伤口侵入患者体内。侵入之后会在患者的体内潜伏一段时间,一定时间之后就会发病,引起炎症的感染。
4、患者自身*力低下:*力比较弱的人,如果日常生活中不注意保养,是很容易患上各种各样的疾病的。有些人*力低下的时候往往是很容易感染非淋的,所以要引起重视。
5、通过接触分泌物传染:非淋的传染性是非常强的,如果未患病者接触了患病者私人衣物或者使用患有非淋菌性尿道炎的病人穿过的衣裤、床上用品、毛巾、浴盆、坐式马桶的话也是会间接传染的。
非淋菌性尿道炎的诊断:
1、有婚外性接触史或配偶感染史,潜伏期1周~3周。
2、临床表现男性常有尿道内刺痒、烧灼感、刺痛,有时尿急及排尿困难。但症状一般比淋病轻。尿道口充血或红肿,有浆液性、粘液脓性或白色稀薄分泌物,或晨起有“糊口”现象。女性发生尿道炎可有尿频、尿急或排尿困难;宫颈炎则白带增多,宫颈充血或红肿、糜烂;阴道及外阴瘙痒等。无论男性或女性有很多病人无症状或症状很轻微,尤以女性为多。
3、本病可经产道传染,引起新生儿眼结膜炎、肺炎、鼻炎、中耳炎和女婴的阴道炎。
4、合并症男性主要合并症为附睾丸炎,前列腺炎及Reiter综合征等;女性主要为输卵管炎、盆腔炎、异位妊娠及不育症等。
5、化验检查
(1)分泌物涂片和培养淋球菌均为阴性,而涂片镜检,在油镜(1000倍)视野下多形核白*超过4个或者晨尿,前段尿15毫升沉淀,在高倍(400倍)视野下,每视野多形核白*超过15个,有诊断意义。
(2)有条件可作沙眼衣原体、解脲支原体等病原学检查。

非淋菌性尿道炎图片
非淋菌性尿道炎的症状:
1、尿道分泌物:尿道分泌物少,稀薄,粘液性或粘膜脓性。较长时间不排尿(如晨起)尿道外口可溢出少量稀薄分泌物。有时仅表现为晨起痂膜封住尿道口或污染内裤。检查时,需由后向前按挤前尿道才可能有少许分泌物由尿道口溢出。有时病人有症状无分泌物,也可无症状而有分泌物。
2、尿道综合症状:起病不如淋病急,症状拖延,时轻时重,但比淋病轻。约50 的病人有尿痛、尿道痒等症状。初诊时很易被漏诊。男性非淋菌性尿道炎表现为尿道不适、发痒、烧灼感或刺疼,尿道红肿,尿道分泌物多为浆液状、稀薄、晨起有“糊口”现象。
女性非淋菌性尿道炎表现为宫颈的炎症和糜烂、分泌物增多,宫颈分泌物中有多数分叶型白*(高倍镜下每视野超过10个),阴道及外阴瘙痒,下腹不适感。
3、常与淋病同时感染:前者先出现淋病症状,经抗淋病治疗后,淋球菌被青霉素杀死,而衣原体、支原体依然存在。在感染1-3周后发病。临床上很易被误认为淋病未治疗或复发。
非淋菌性尿道炎的预防:
1、治疗期间不许饮酒。当完成一个疗程后应进行随访。患者是否按时、按量治疗。因为非淋菌性尿道炎的治疗不同于淋病能做到短期足量治疗,而且服药次数多,持续时间长,患者容易因公因事而忘记服药,或者1--2天后基本消失而停服,影响 或复发。此时不要急于改换y a o物。
2、由于目前有多达45 的淋病患者在感染淋球菌的同时也感染衣原体和支原体,因此,在治疗淋病时,可采取同时治疗非淋菌性尿道炎联合方案。
3、性伴侣如有感染应同时治疗。经治疗,病人的症状持续存在,或症状消失后又复发,较可能的原因是性伴侣未经治疗。未经治疗与性伴侣性交,病菌由未经治疗的性伴侣再次传给患者。须知有40 的非淋菌性尿道炎患者是没有症状。所以不但患者本身要治疗,其性伴侣也应接受预防性的y a o物治疗。这是非淋菌尿道炎防治中必不可少的一项,做好了这一项就能够防止非淋性尿道炎反复发作了。
4、对于已经多所医院治疗而未愈的患者。要详细了解病情和疗程,若按正规诊疗而无好转或无效者,应改换另一种方法,中西y a o结合治疗,多种西y a o联合治疗。联合治疗时一般不要用同类抗生素。如果患者反复发作,应警惕并发症,如前列腺炎等,应做相应的细菌学查,并及时治疗。有条件的医疗单位,应对每一患者尤其是复发者做详细的临床和细菌查,并进行针对性的治疗,这样才能*治疗。
非淋菌性尿道炎图片
非淋菌性尿道炎的危害:
非淋菌性尿道炎,主要由衣原体、支原体化脓所致,此外还可由其他微生灵所产生,如梭状杆菌、包皮杆菌、白色念球菌、阴道滴虫等。四非特异性化脓者,抗生素尿道炎治疗结果好,急性期应留意休假,避免性生息,补可意够液体,有标准病变者定时治疗原有病变,如糖尿病患者应把握血糖,包皮过长、包茎行包皮环切术。在男性非淋性尿道炎治疗性播送疾病时,应留意到淋病与非淋菌性尿道炎有错杂化脓。
在非特异性化脓中,致病菌以大肠杆菌、链球菌和葡萄球菌较常见。尿道炎常因尿道口或尿道内阻塞所产生,如包茎、后尿道瓣膜、尿道狭小、尿道结石等。非淋菌性尿道炎常称淋病,是由淋病双球菌化脓产生。淋球菌在炎热或超脱60摄氏度四周中短暂间内灭活。患者浮现腹股沟淋恭维肿大,约1周后症状逐步减弱,约4-8周后症状可消逝,但尿道口晨间仍有少量粘液。
专家指出:非淋菌性尿道炎诱发不孕不育症。非淋逆行感染,感染到男性前列腺、精囊腺和附睾。会使精子产生异常,患不育症。女性可以感染到宫颈、子宫内膜、输卵管等等,引起不孕症。引发排尿障碍。尿痛轻微,排尿时仅感到尿道灼热或轻度刺痛,常可见终末血尿。患者常主诉尿道口红肿、灼痛等,严重者甚至引发排尿障碍等重症。导致性功能障碍。
患了非淋如果没有得到及时、科学地治疗,久而久之,容易导致男性出现性欲减退、勃起不坚、阳痿、早泄及神经衰弱等症状。并发其他病症。如急性附睾炎、前列腺炎、精囊炎、尿道腺炎、尿道周围组织炎和脓肿、精囊炎、鞘膜积液、睾丸炎、结肠炎等;其中以附睾炎或前列腺炎居多。

非淋菌性尿道炎图片
非淋菌性尿道炎的护理:
一:治疗结果不佳要及时改变方案。对于已经多所医院治疗而未愈的患者,要详细了解病情和疗程,若按正规诊疗而无好转或无效者,应改换另一种方法,甚至联合治疗。联合治疗时一般不要用同类抗生素。
二:必要时采取综合治疗。由于目前有多达45 的淋病患者在感染淋球菌的同时也感染衣原体和支原体,因此,在治疗淋病时,可采取同时治疗非淋菌性尿道炎联合方案。
三:性伴侣同时治疗。经治疗,病人的症状持续存在,或症状消失后又复发,较可能的原因是性伴侣未经治疗。未经治疗与性伴侣性交,病菌由未经治疗的性伴侣再次传给患者。须知有40 的非淋菌性尿道炎患者是没有症状。所以不但患者本身要治疗,其性伴侣也应接受预防性的药物治疗。方法与患者相同,如为孕妇,可用红霉素或阿莫西林治疗。
四:按时、按量治疗。因为非淋菌性尿道炎的治疗不同于淋病能做到短期足量治疗,而且服药次数多,持续时间长,患者容易因公因事而忘记服药,或者1~2天后基本消失而停服,影响 或复发。此时不要急于改换药物。
五:注意少见病原体。若为滴虫、霉菌或其他少见病,尤其是霉菌性尿道炎,不能一味加用素,否则对患者危害更大,应查清后对症治疗。
六:禁止滥用抗生素。非淋菌性尿道炎治疗时不应滥用抗生素,如绝大多数青霉素药物对衣原体、支原体均无效,一般不应使用。磺胺对衣原体而对支原体均无效,链霉素大观霉素对衣原体无效对支原体,庆大霉素、新霉素、多粘菌素对衣原体无效。
温馨提示:以上的内容就是由北京京城皮肤医院为大家详细介绍的关于非淋菌性尿道炎的全部内容,相信大家看完之后,对该疾病都有了一定的认识,也都知道了它是一种严重的性传播疾病,一旦患有给我们的正常生活带来了较大的困扰。因此我们在平时的生活中一定要积的预防。要对该疾病引起重视。专家建议一旦患有该疾病的患者,一定不要不好意思,一定要及时的到正规的皮肤病医院进行专业的检查和治疗,切勿盲目的用药,以免造成误诊,带来病情的加重,给治疗增加难度。